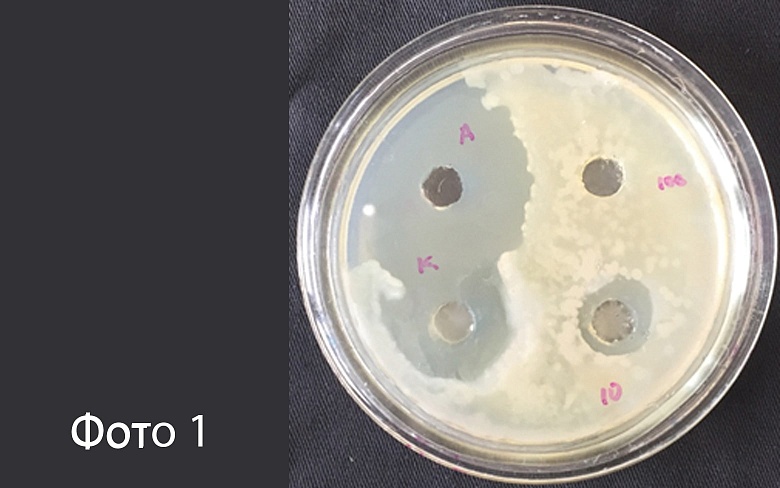

Молочнокислые бактерии в растениеводстве: перспективы применения
01 февраля 2021, 11:18
Научно-практический журнал БИОМ №1 2018

Молочнокислые бактерии — это общее название бактерий семейства Lactobacillaceae, основным свойством которых является способность образовывать молочную кислоту в качестве основного продукта брожения. Но, помимо молочной кислоты, в процессе своей жизнедеятельности эти бактерии образуют большое количество биологически активных веществ, в том числе обладающих антимикробной активностью. Уникальные свойства молочнокислых бактерий широко используются в медицине, пищевой промышленности, кормопроизводстве, ветеринарии.
Лактобациллы в растениеводстве
Но только относительно недавно их стали применять в растениеводстве для защиты растений и повышения урожайности. Хотя о пользе молочнокислых бактерий для растений было известно еще давно. Например, многим известен народный рецепт борьбы с мучнистой росой: опрыскивание зараженных листьев молочной сывороткой. Ранее считалось, что такой эффект связан с образованием на поверхности листьев пленки, «не позволяющей дышать грибу», но очевидно, что такое возможно, главным образом, из-за содержащихся в сыворотке молочнокислых бактерий и продуктов их метаболизма, биологически активных веществ.
На сегодняшний день известно, что молочнокислые бактерии, в частности, лактобациллы, обнаруживаются на всей поверхности растений, но особенно их много в ризосфере. В больших количествах они присутствуют в разлагающихся растительных остатках. Согласно теории Т. Хига, лактобациллы входят в число так называемых «эффективных микроорганизмов» (EM, Effective Microorganisms), которые оказывают положительное воздействие на растения и способствуют более высоким урожаям. Лактобациллы действительно эффективны благодаря своей высокой антагонистической активности в отношении растительных патогенов, они способны защитить растения от биотических стрессов. К тому же подавляющее большинство молочнокислых бактерий имеют GRAS статус, т.е. признаны безопасными для человека и животных.
Антибактериальная активность лактобацилл
Антибактериальную активность лактобацилл, чаще всего, связывают с образованием бактериоцинов, которые также называют лантибиотиками. Это антимикробные пептиды бактериального происхождения, в состав которых входят такие редкие тиоэфирные аминокислоты, как лантионин и метиллантионин. Эти вещества имеют широкий антибактериальный спектр действия. Механизм биологического действия лантибиотиков, в том числе низина, неплохо изучен и связан с нарушением проницаемости бактериальных цитоплазматических мембран. Разработаны препараты для для борьбы с бактериозами растений. Например, препарат Бинал Экстра, содержащий клетки и метаболиты Lactobacillus plantarum, способен подавлять целый спектр фитопатогенных бактерий, в том числе Agrobacterium sp. и Erwinia sp., что было доказано в ходе лабораторных и полевых испытаний.
Фото 1 (Подавление роста тест штамма A.tumifaciens культуральной жидкостью L.plantarum при разных разбавлениях)
И только относительно недавно, с 2007 года, в передовых зарубежных и отечественных научных публикациях стали появляться сведения об обнаружении среди метаболитов веществ с фунгицидными свойствами. Среди них были обнаружены органические и жирные кислоты, белковые соединения, циклические дипептиды, фенольные соединения и даже перекись водорода. Было доказано, что в комплексе антигрибковые вещества молочнокислых бактерий Lactobacillus plantarum сдерживают рост Botrytis cinerea, Fusarium oxysporum, Phytophthora drechsleri, и некоторых других фитопатогенных грибов.
Производственные испытания
С целью проверки фунгицидной активности молочнокислых бактерий, в конце прошлого года впервые были проведены полевые испытания препарата Бинал Экстра на основе клеток и метаболитов Lactobacillus plantarum на мучнистой росе огурца. Как известно, это широко распространенное и чрезвычайно вредоносное заболевание в теплицах. Возбудитель мучнистой росы огурца – гриб подкласса Эризифовые Oidium erysiphoides (половая стадия Sphaerotheca fuliginea) – облигатный паразит, что делает невозможным его выделение и изучение в лаборатории стандартными методами, поэтому все испытания проводят на вегетирующих растениях. В тоже время бороться к этим заболеванием все труднее: гриб обладает высокой генетической адаптивностью к химическим фунгицидам, отчего их эффективность быстро снижается, и требуется частая ротация препаратов, что в свою очередь приводит к увеличению агрессивности фитопатогена.